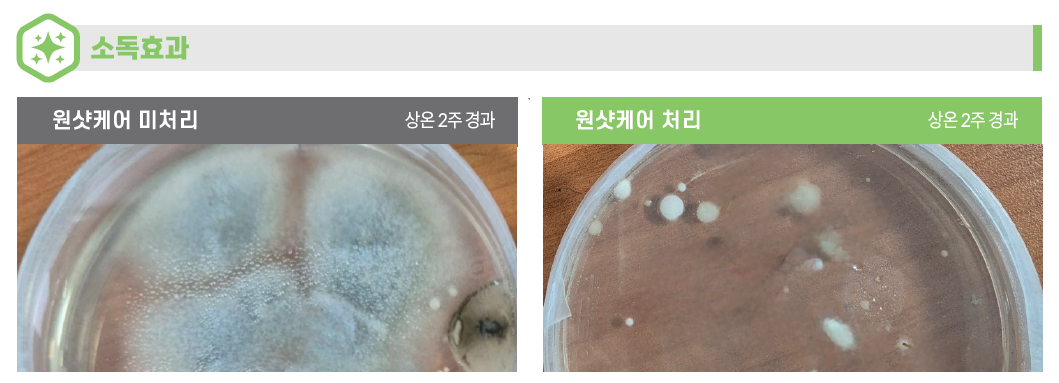

곰팡이·세균 차단으로 고품질 사과 저장
[농축환경신문] 수확의 기쁨만큼이나 중요한 과정은 ‘저장’이다. 정성껏 재배한 농산물도 저장 과정에서 부패하거나 상품성이 저하될 경우 농가 수익에 직접적인 영향을 미친다. 이에 농산물 수확 후 관리 전문 기업 ㈜탑프레쉬는 지난해 출시 이후 농가들로부터 호응을 얻고 있는 저장고 소독제 ‘원샷케어’를 사과 장기저장을 위한 첫 단계 솔루션으로 제시했다.
탑프레쉬가 제안하는 ‘사과 장기저장 솔루션’은 ‘원샷케어(소독) → 일라이트 저장비닐 → 스마트스틱(신선도 유지) → 스마트 환기시스템’으로 이어지는 체계적인 관리 프로세스로 구성된다. 이 가운데 첫 단계인 ‘원샷케어’는 저장고 내부에 잠복해 있는 곰팡이와 유해 세균을 제거해 입고되는 농산물의 감염을 사전에 차단하는 역할을 한다.
‘원샷케어’의 가장 큰 장점은 안전성과 편의성이다. 농약 성분이 아닌 식품첨가물 기반으로 제조돼 잔류 걱정 없이 사용할 수 있으며, 원터치 방식으로 설계돼 별도의 장비 없이도 간편하게 소독이 가능하다. 또한 작업 시간과 노동력을 줄여 효율적인 관리에 도움을 준다.

제품의 효과를 극대화하기 위해서는 올바른 사용 방법을 준수하는 것이 중요하다. ‘원샷케어’는 반드시 농산물이 없는 빈 저장고 상태에서 사용해야 하며, 과일이나 채소가 입고된 상태에서는 사용이 금지된다. 다만 콘티박스나 농기계는 저장고 내부에 함께 두고 소독할 수 있다.
사용 기준은 저장고 면적 10평당 1개이며, 에어로졸 형태로 자동 분사돼 저장고 내부 구석이나 높은 벽면 등 기존 분무 방식으로 접근하기 어려운 공간까지 고르게 소독할 수 있다. 처리 후에는 최소 6시간 이상 밀폐 상태를 유지해 소독 효과를 높이고, 이후 문을 열어 24시간 이상 충분히 환기한 뒤 농산물을 입고하는 것이 바람직하다.
탑프레쉬 관계자는 “원샷케어는 정성껏 재배한 농산물을 부패 없이 장기간 보관할 수 있도록 돕는 제품”이라며 “본격적인 저장 시즌을 앞두고 철저한 소독을 통해 고품질 사과의 가치를 끝까지 유지하시길 바란다”고 말했다.
[저작권자ⓒ 농축환경신문. 무단전재-재배포 금지]






























